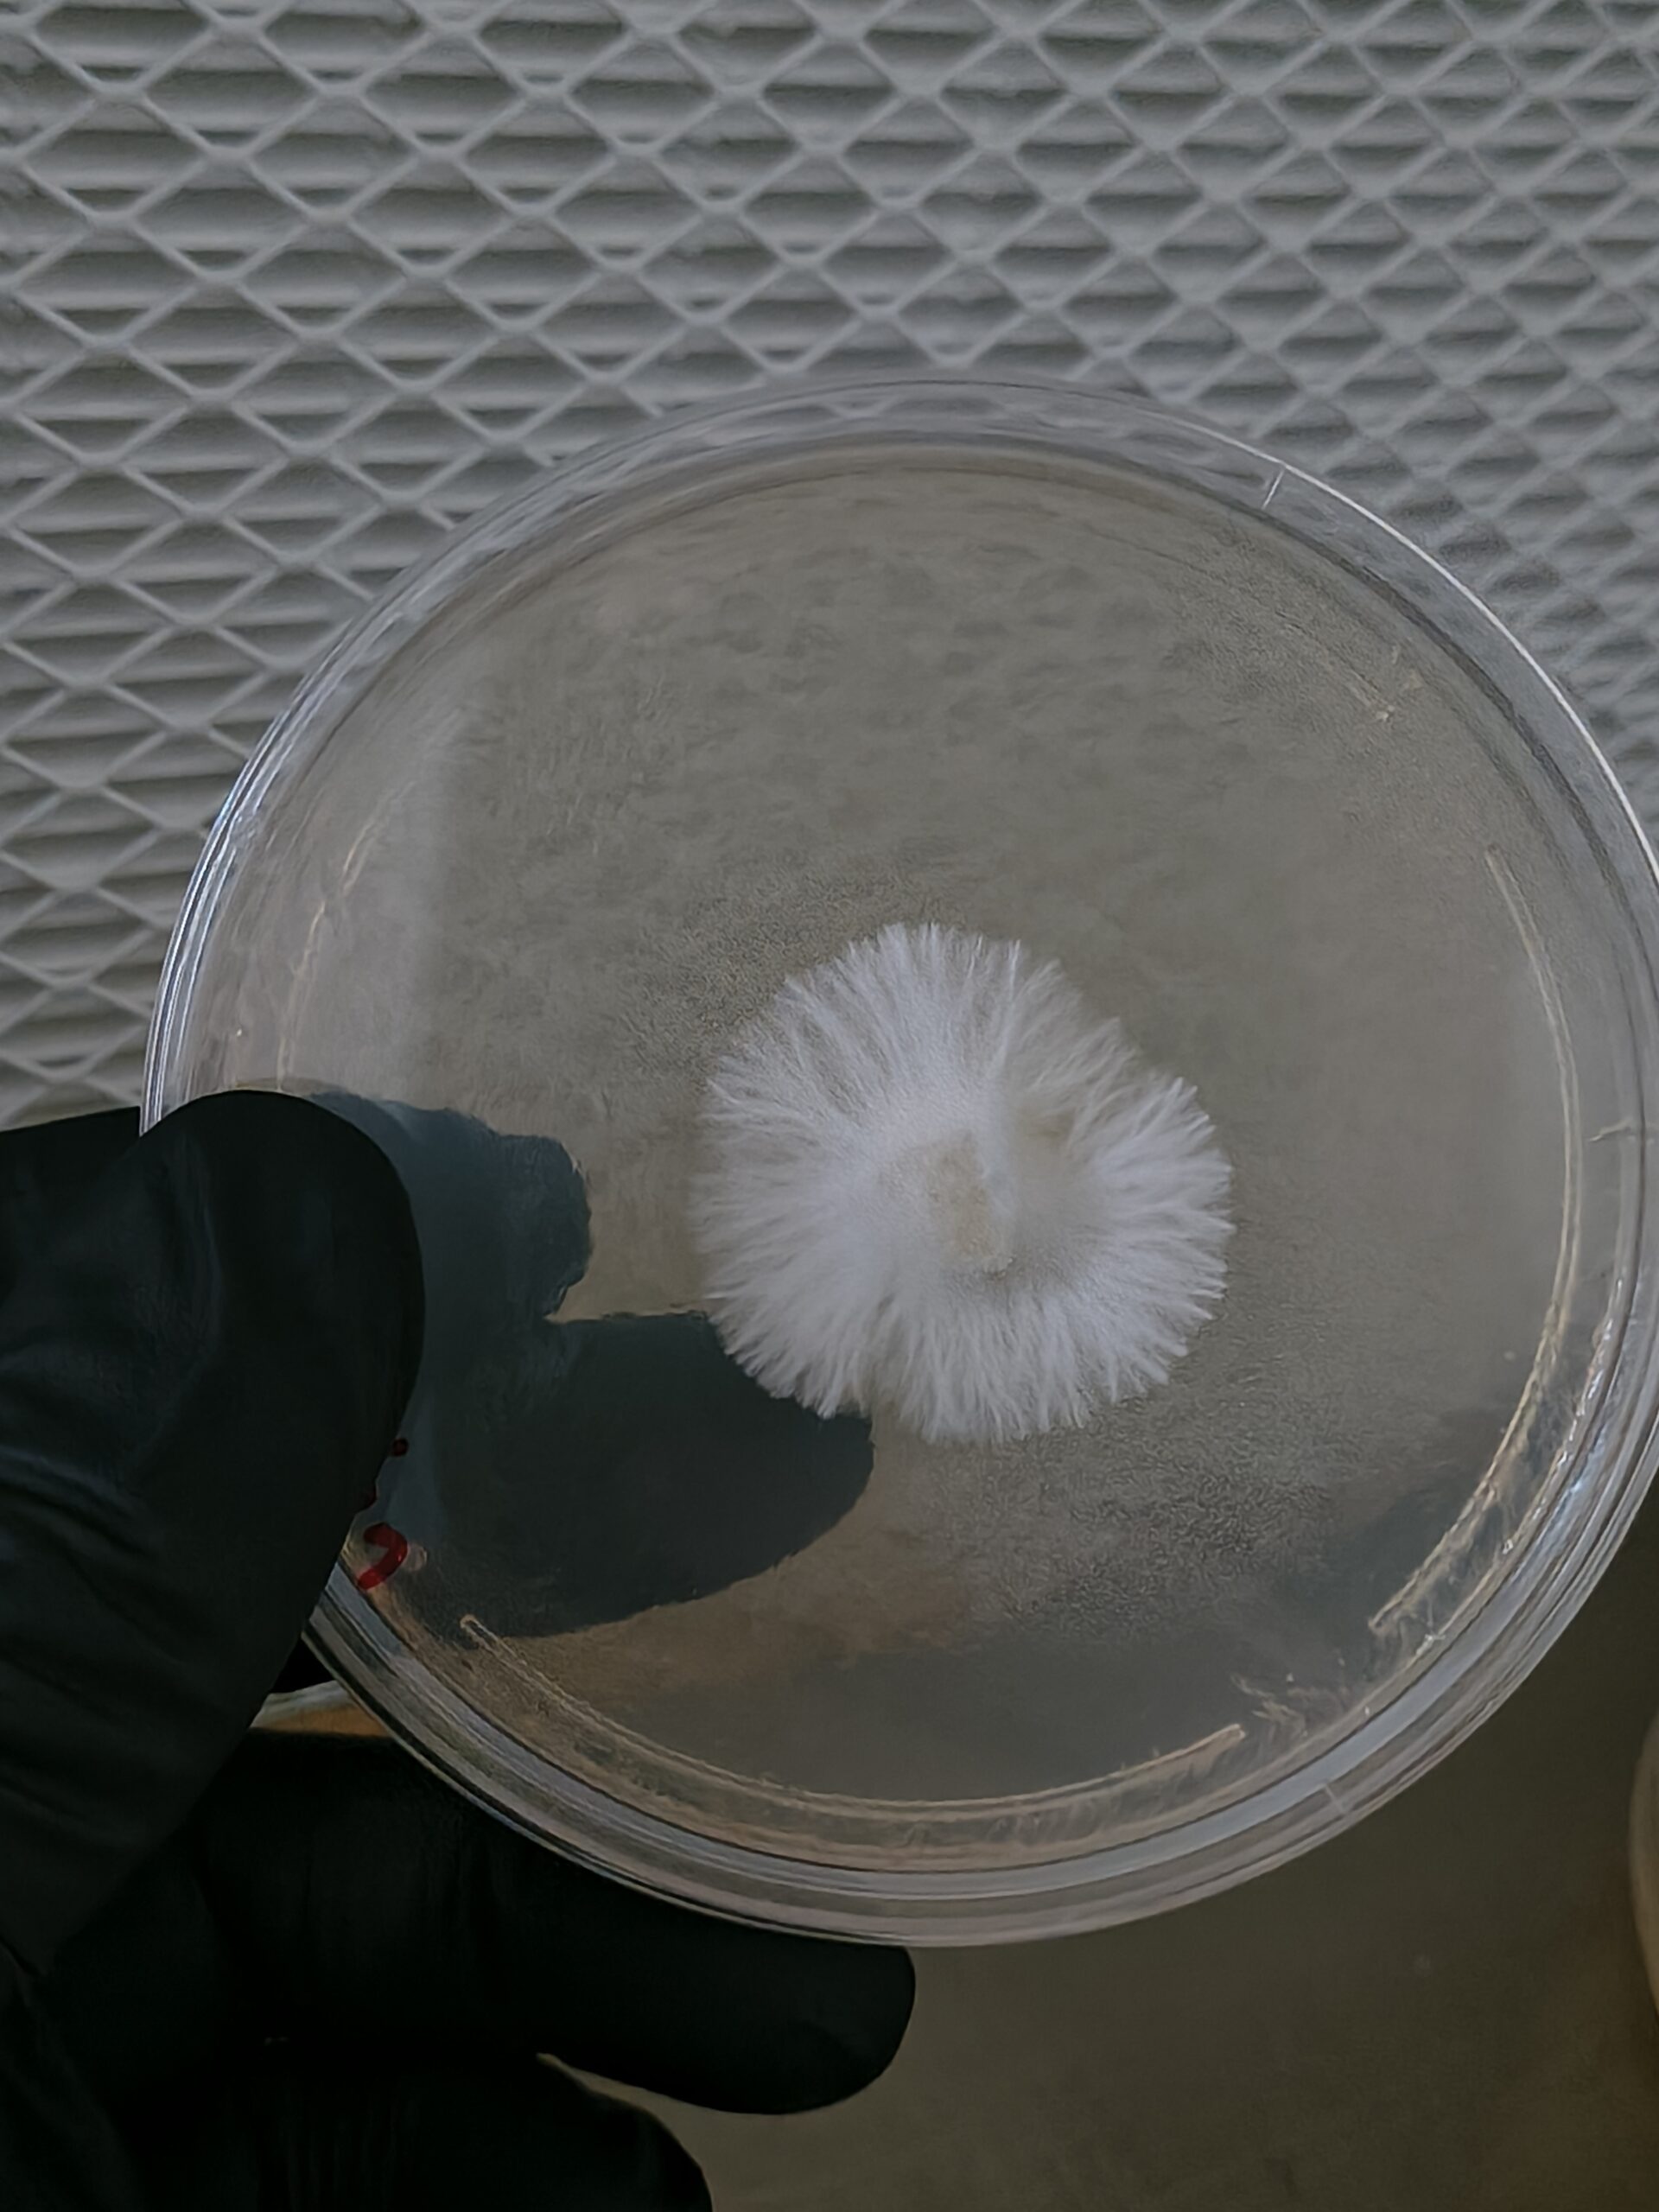
Huatla Research Plate
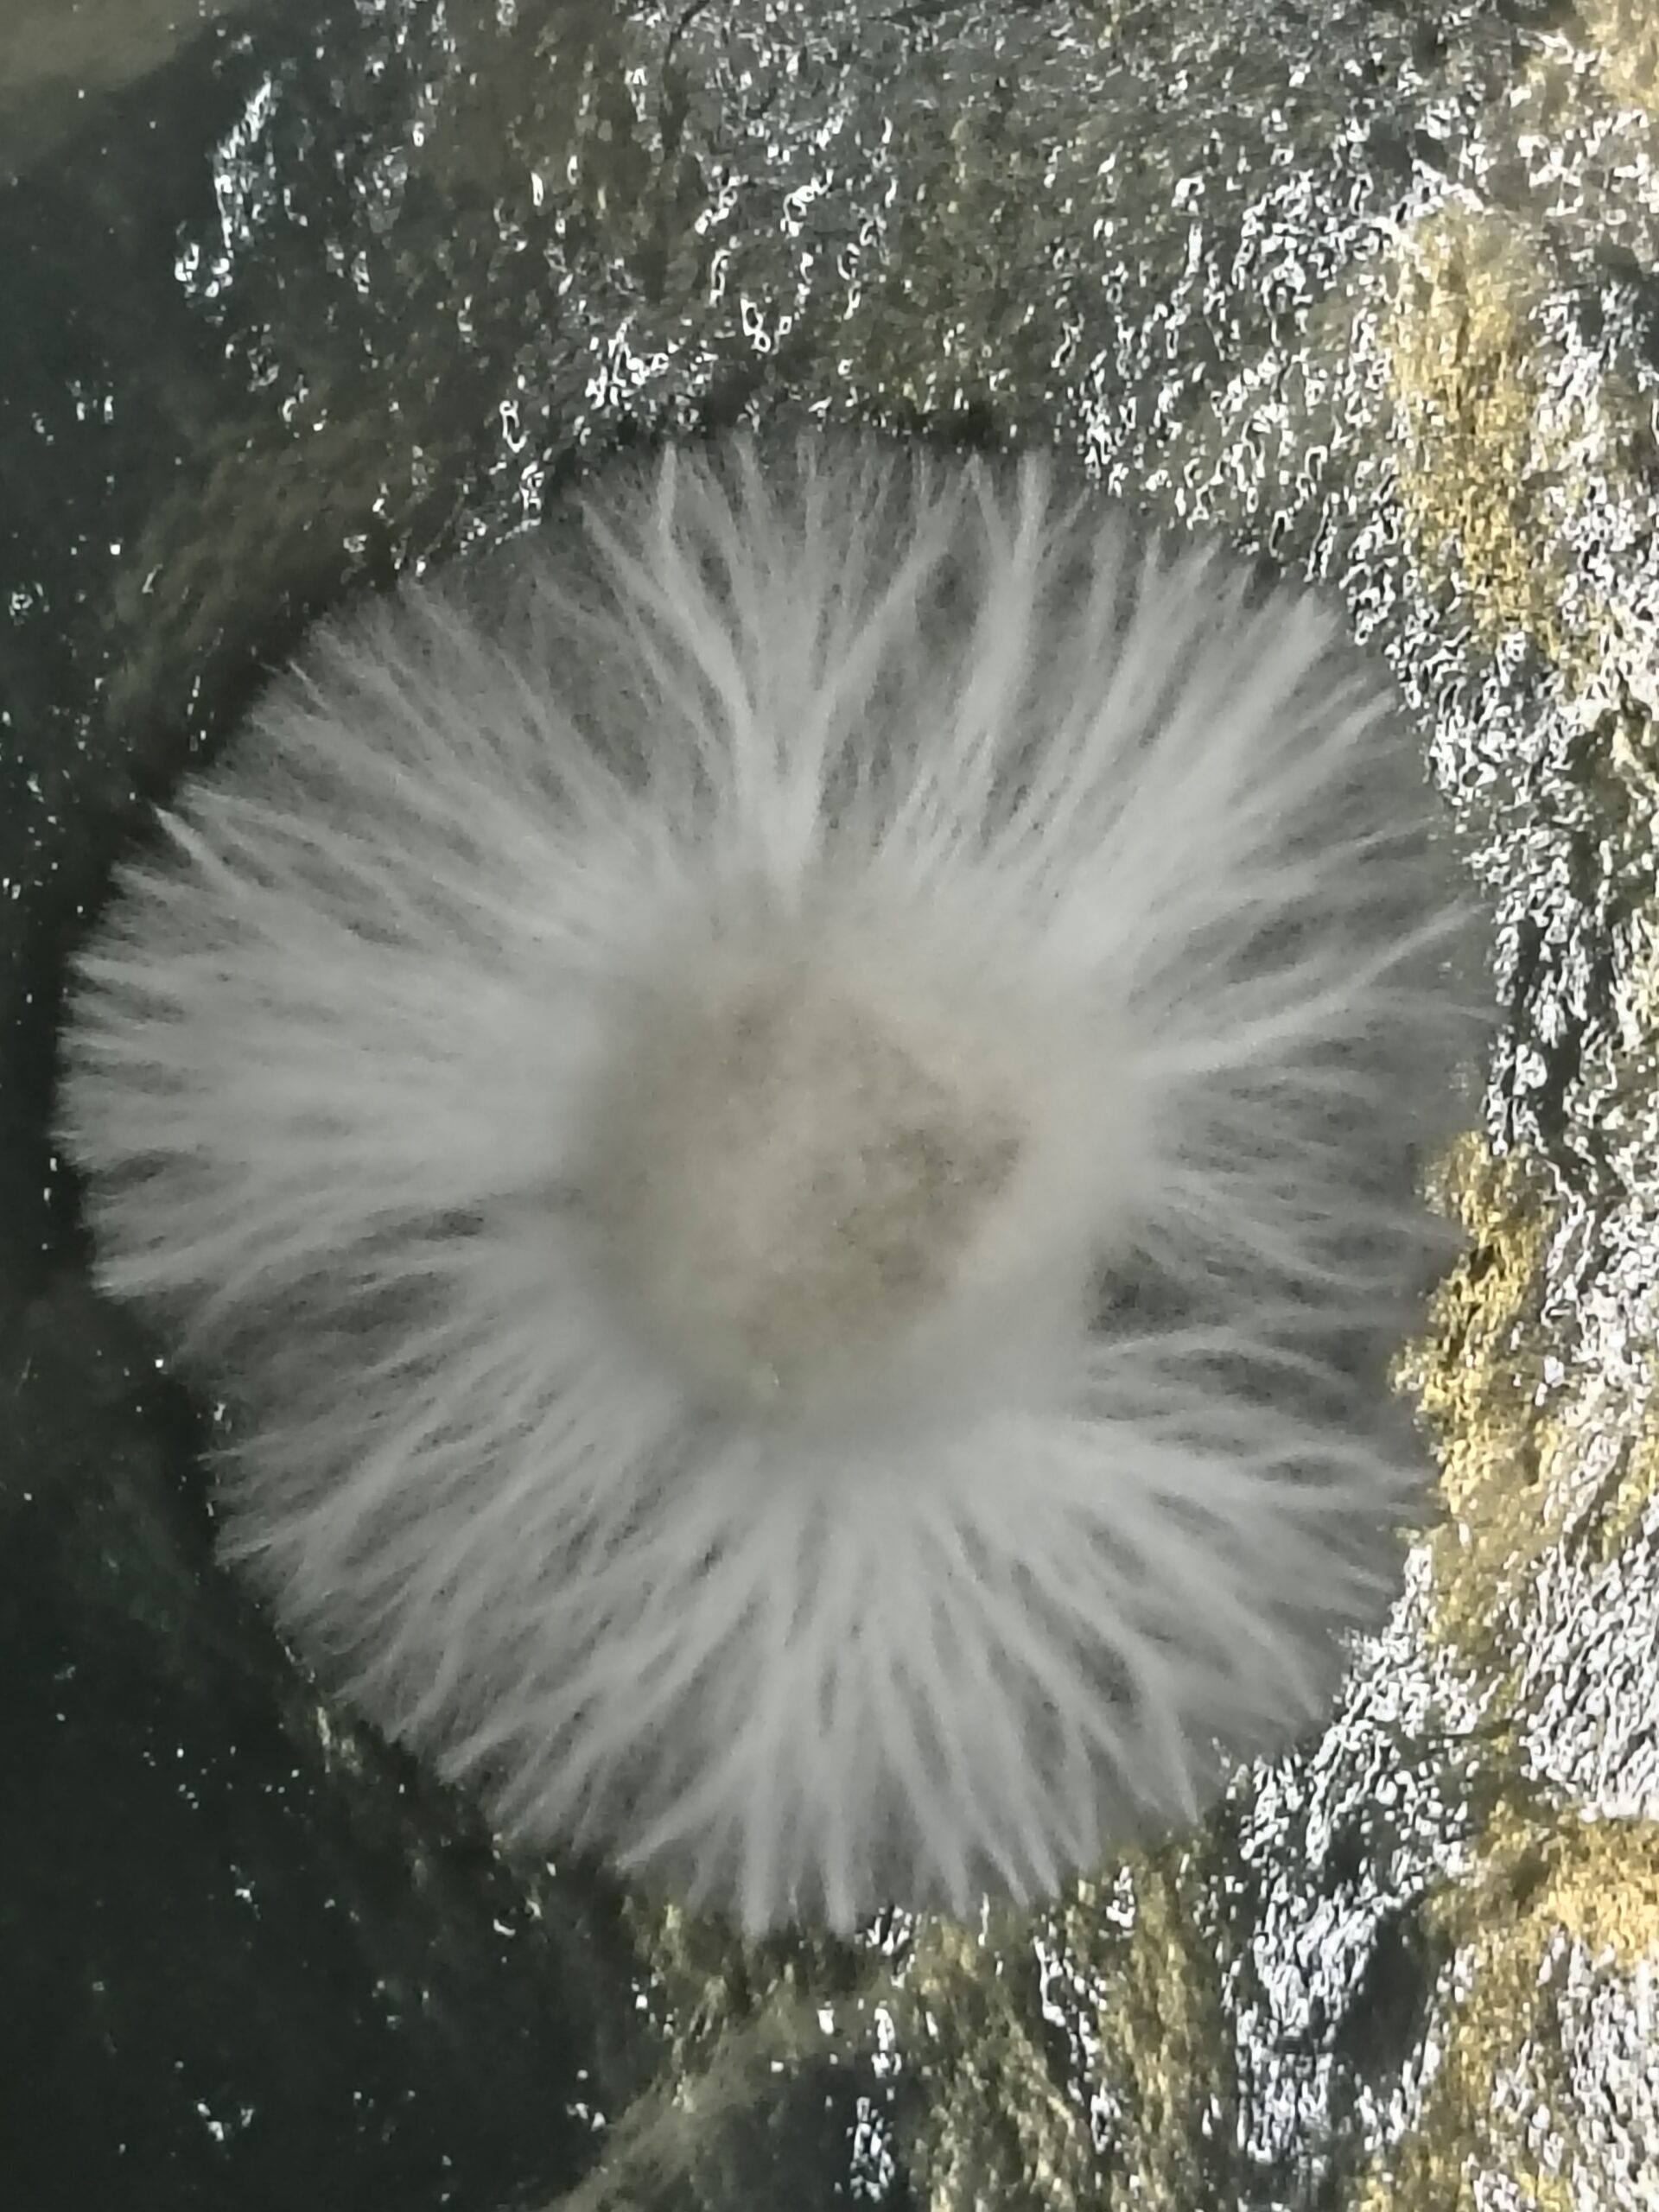
Huatla Research Plate - Image 2
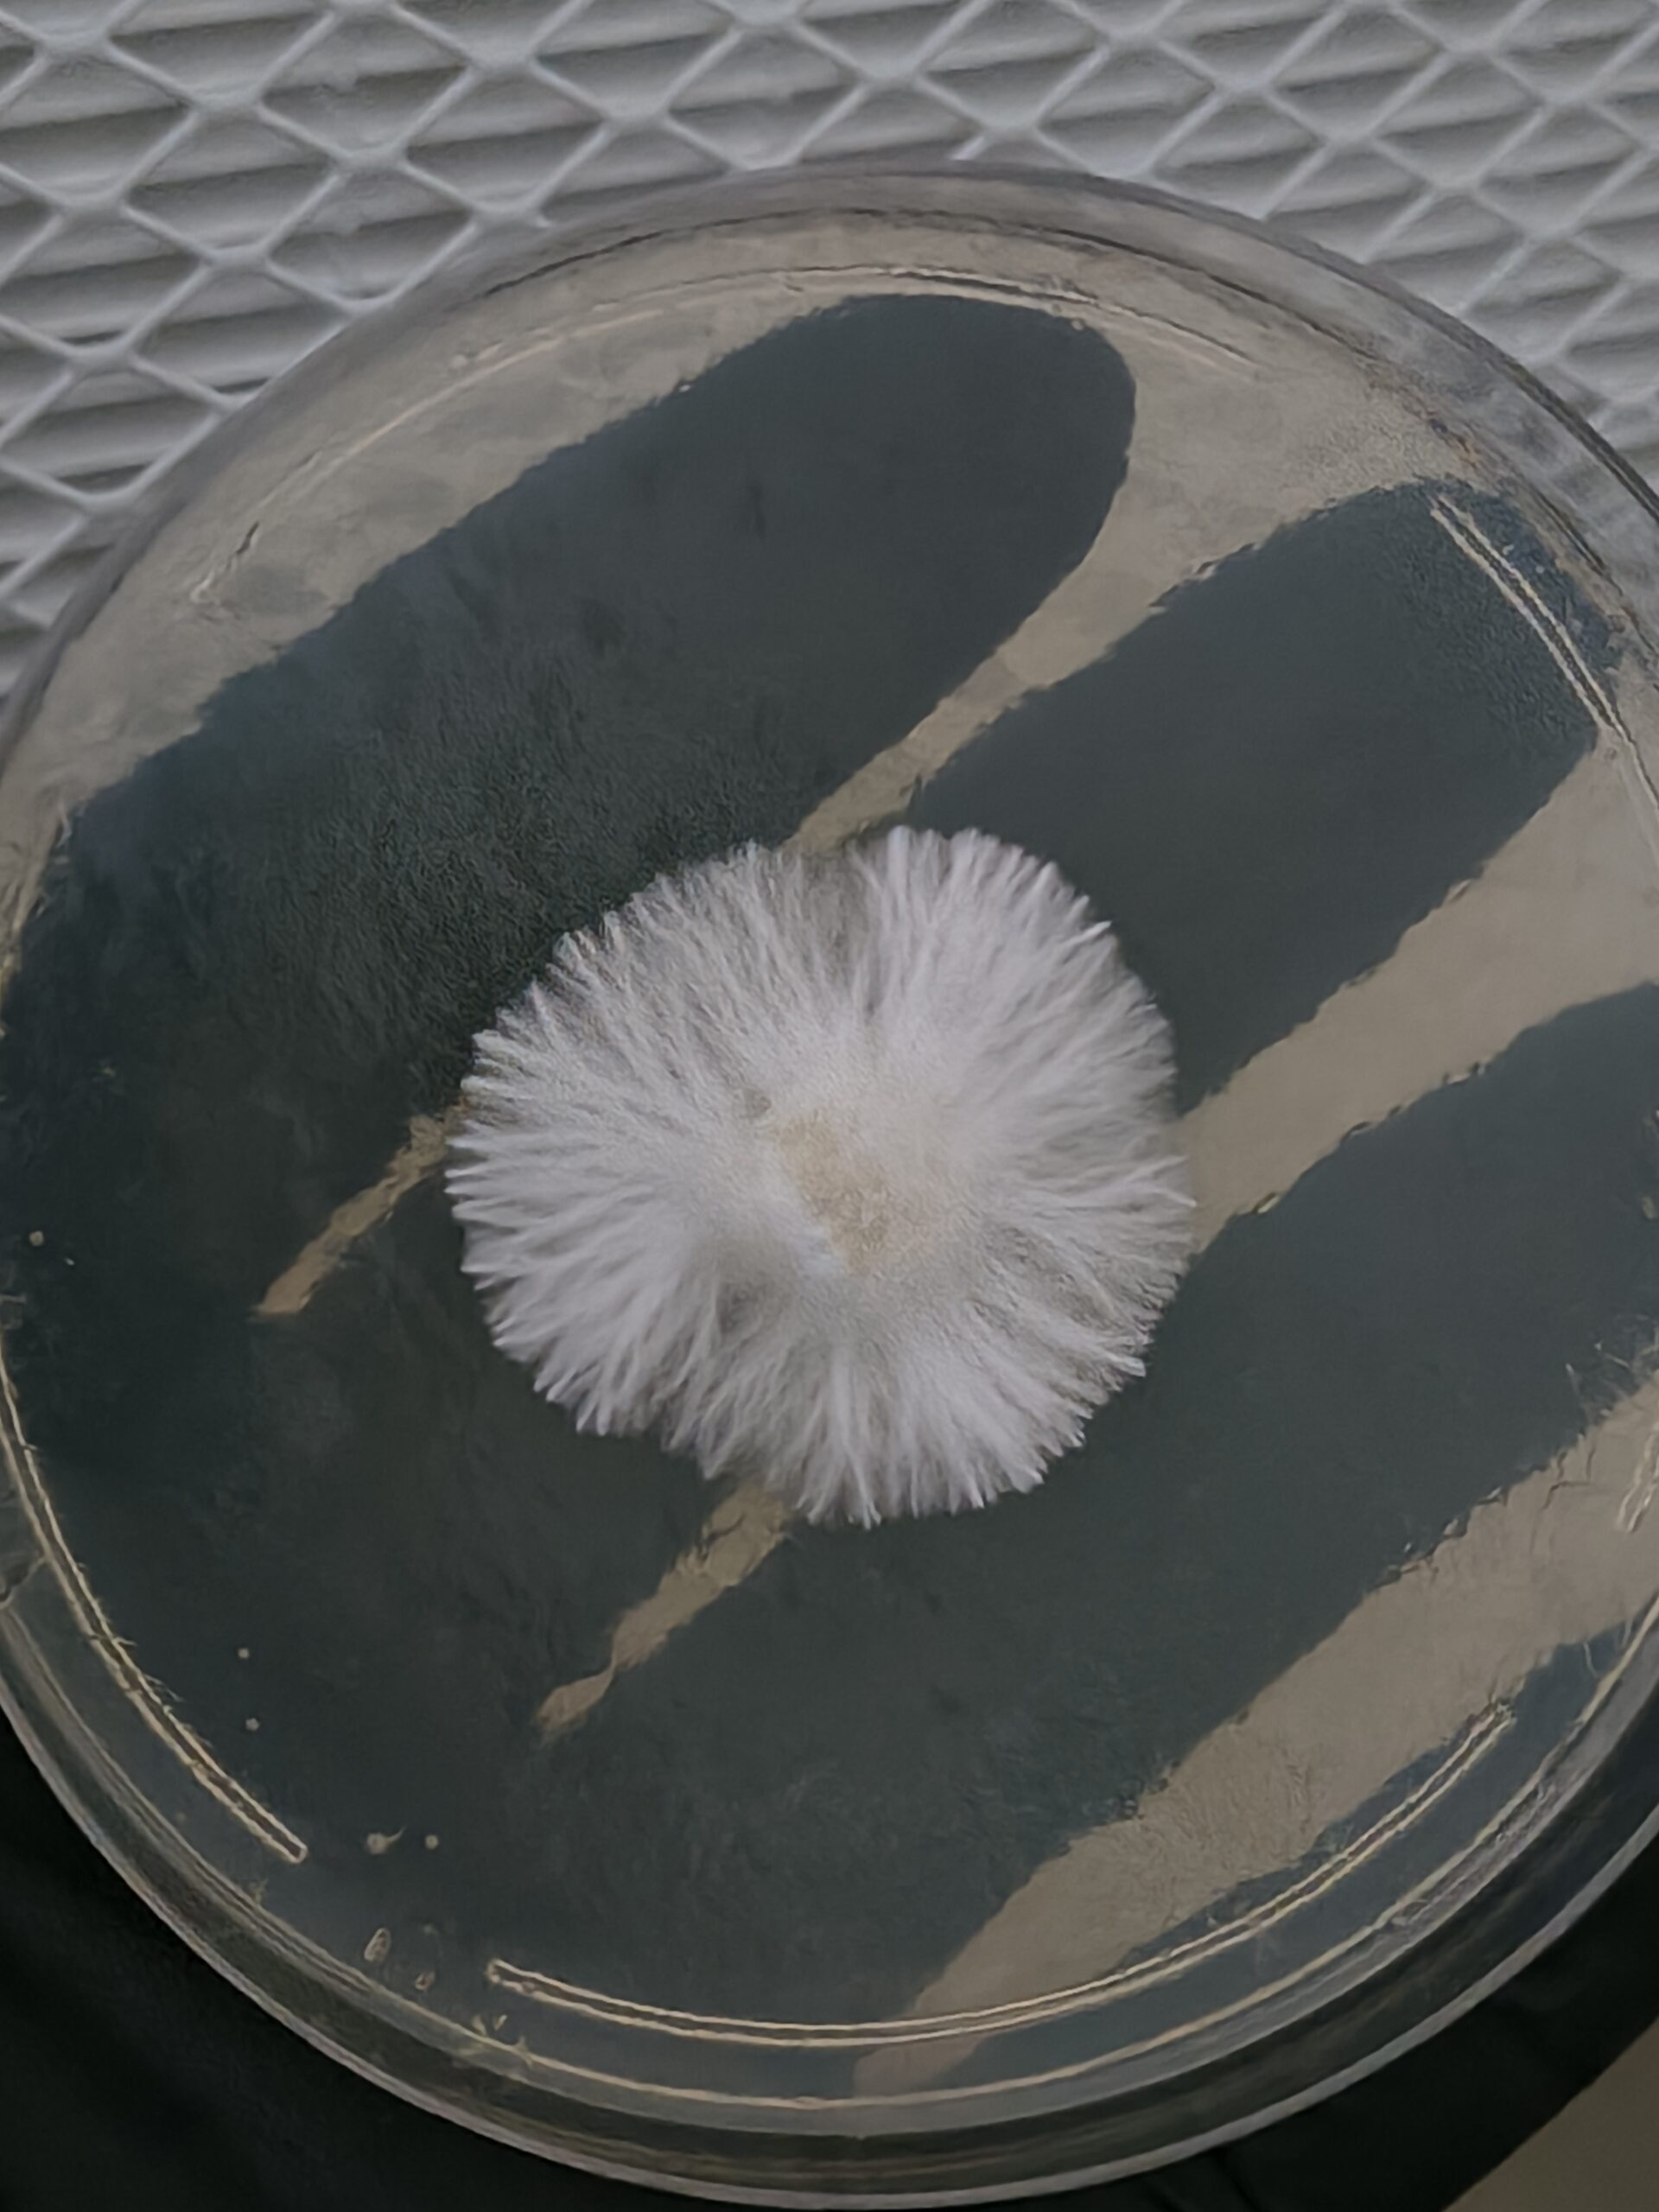
Huatla Research Plate - Image 3

Only logged in customers who have purchased this product may leave a review.
Marvelous Mikes Fungal Forge
Huatla Research Plate
Original price was: $15.00.$12.00Current price is: $12.00.
The Huautla Research Culture: The Perfect Choice for Beginners (pronounced Wat-la)
Welcome to the Forge! If you are just starting your journey into the world of mycology, the Huautla strain is widely considered one of the best “entry-level” varieties available. Sourced from the historic Sierra Mazateca region of Mexico, this culture is as resilient as it is famous.
Why it’s Beginner-Friendly:
Forgiving Nature: Huautla is known for being incredibly robust. It handles environmental fluctuations better than “designer” strains, making it much easier for those still perfecting their lab technique.
Fast & Visual Growth: This culture produces aggressive, rope-like (rhizomorphic) mycelium. It’s exciting to watch because it colonizes quickly, giving beginners fast results and clear visual feedback under the microscope.
Classic Genetics: Unlike finicky hybrids, the Huautla is a stable, reliable performer. It’s the “Old Faithful” of the fungal world—dependable, sturdy, and a joy to study.
Whether you are looking for your very first research project or just want a low-stress addition to your library, the Huautla is the gold standard for ease of use.
(Note: This culture is sold strictly for microscopy, taxonomy, and legal research purposes only.)
Availability: In stock
Units Sold: 0
Shipping costs
| Shipping from | United States (US) |
| Within United States (US) | $8.00 |
National Shipping Details
| Minimum shipping charge per order | $8.00 |

Reviews
There are no reviews yet.